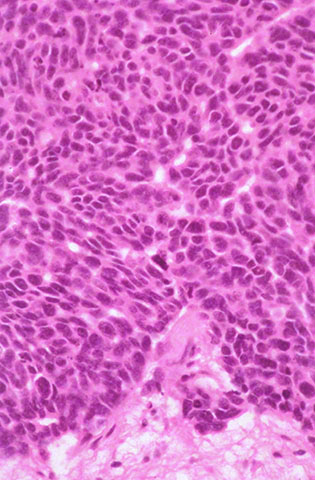

NBME 33 – Block 2
Time limit: 0
Quiz Summary
0 of 20 Questions completed
Questions:
Information
You have already completed the quiz before. Hence you can not start it again.
Quiz is loading…
You must sign in or sign up to start the quiz.
You must first complete the following:
Results
Quiz complete. Results are being recorded.
Results
0 of 20 Questions answered correctly
Your time:
Time has elapsed
You have reached 0 of 0 point(s), (0)
Earned Point(s): 0 of 0, (0)
0 Essay(s) Pending (Possible Point(s): 0)
Categories
- Not categorized 0%
- 1
- 2
- 3
- 4
- 5
- 6
- 7
- 8
- 9
- 10
- 11
- 12
- 13
- 14
- 15
- 16
- 17
- 18
- 19
- 20
- Current
- Review
- Answered
- Correct
- Incorrect
-
Question 1 of 20
1. Question
A 56-year-old woman undergoes pancreatectomy because of a mass in the head of the pancreas which has obstructed the common bile duct and produced jaundice. The mass is identified as a malignant neoplasm. The surrounding pancreas shows atrophy of the acinar tissue. Which of the following is the most likely cause of these findings?
CorrectIncorrect -
Question 2 of 20
2. Question
A 5-year-old boy has a decreased hematocrit and hemoglobin concentration. Measurement of total iron-binding capacity shows that most of his transferrin is unsaturated. Which of the following describes the most likely condition of this patient’s iron stores?
CorrectIncorrect -
Question 3 of 20
3. Question
A 64-year-old man comes to the physician because of an intensely itchy generalized rash. Physical examination shows generalized erythema and several indurated plaques and nodules. A photograph of the face is shown. There is axillary and inguinal lymphadenopathy. Skin biopsies show a dense cell infiltrate in the mid to upper dermis with invasion of the infiltrate into the epidermis. The contours of the nuclei of the cells in the infiltrate are markedly irregular and convoluted. Similar cells are found in the buffy coat of the peripheral blood. This dermal infiltrate is most likely composed of which of the following cells?
 CorrectIncorrect
CorrectIncorrect -
Question 4 of 20
4. Question
A 34-year-old Mexican American man comes to the physician for a health maintenance examination. He is active on an intramural basketball team, enjoys his job, and has three children. He eats spicy, salty food prepared by his wife at almost every meal. He says, “Sometimes I think maybe all that salt isn’t good for me, but my father ate food like this his entire life and he never had any health problems.” He is 173 cm (5 ft 8 in) tall and weighs 68 kg (149 lb); BMI is 23 kg/m2. His blood pressure is 159/96 mm Hg. Physical examination shows no other abnormalities. Similar blood pressure readings are obtained on two subsequent visits. Antihypertensive therapy is initiated. Which of the following is the most appropriate statement by the physician regarding this patient’s sodium intake?
CorrectIncorrect -
Question 5 of 20
5. Question
A 65-year-old woman with a 2-year history of mitral stenosis comes to the physician because of cough productive of frothy fluid after mild exercise, shortness of breath with exertion, and wheezing. She says that she needs two pillows to help her breathe while sleeping. Her pulse is 115/min, respirations are 22/min, and blood pressure is 110/90 mm Hg. There is an accentuated S1 on auscultation of the chest. A chest x-ray shows alveolar infiltrates in the lower lung fields. Which of the following sets of findings is most likely in this patient’s lungs?
Option
Increased Pulmonary Capillary Hydrostatic Pressure
Increased Filtration from Pulmonary Capillaries
Increased Pulmonary Lymph Flow
A
Yes
Yes
Yes
B
Yes
Yes
No
C
Yes
No
Yes
D
Yes
No
No
E
No
Yes
Yes
F
No
Yes
No
G
No
No
Yes
H
No
No
No
CorrectIncorrect -
Question 6 of 20
6. Question
A 55-year-old man comes to the physician because of a 4-week history of dry mouth, muscle weakness, constipation, and episodes of dizziness while standing. He has smoked 2 packs of cigarettes daily for 30 years. Breath sounds are decreased over the right lower lobe. A chest x-ray shows a mass in the right lower lobe. A photomicrograph of a biopsy specimen from the mass is shown. Which of the following mechanisms is the most likely cause of the muscle weakness in this patient?
CorrectIncorrect -
Question 7 of 20
7. Question
A 16-year-old girl is brought to the emergency department because of an 8-hour history of vomiting, a 1-day history of nausea and increasingly severe right flank pain, and a 2-day history of burning pain with urination and increased urinary frequency. She is sexually active with three male partners and uses no contraception. She appears ill and lethargic. Her temperature is 40.2°C (104.4°F), pulse is 140/min and regular, respirations are 16/min, and blood pressure is 100/50 mm Hg. Pulse oximetry on room air shows an oxygen saturation of 100%. Physical examination shows marked right costovertebral angle tenderness. Cardiac examination shows no murmurs. The abdomen is soft and nontender. Pelvic examination shows no abnormalities. A urine pregnancy test result is positive. Laboratory studies are pending. Which of the following infectious agents is the most likely cause of the findings in this patient?
CorrectIncorrect -
Question 8 of 20
8. Question
A 21-year-old woman is brought to the emergency department by police 1 hour after they found her standing in the middle of a highway, shouting. When the police confronted her, she said, “I can control them with my mind.” En route, they learned that she had been on a cross-country bus trip but had been asked to leave the bus; she explained that the bus driver said she was too loud and was flirting too much with the men and women on the bus. She then made sexual advances to the police officers and masturbated in the back seat of the patrol car. She says she has not slept during the past 9 days and adds, “Who has time to waste? I have places to see, people to meet, things to do.” She appears disheveled but healthy. Physical examination shows no abnormalities. On mental status examination, she is grandiose, expansive, and hypersexual. Her speech is rapid. She refuses to undergo cognitive testing. Which of the following is the most likely diagnosis?
CorrectIncorrect -
Question 9 of 20
9. Question
An otherwise healthy 32-year-old woman comes to the physician because of the sudden onset of a painful lump in her vulva 3 days ago. She has had no difficulty with urination or pain with sexual intercourse. Physical examination shows a 2-cm, well-circumscribed, tender, freely mobile mass lateral to the vaginal introitus. The structure involved in the development of this mass most likely originates in which of the following embryologic structures?
CorrectIncorrect -
Question 10 of 20
10. Question
A 62-year-old man is brought to the physician by his wife because of a 2-year history of mental status changes and agitation that have worsened during the past 4 months; he also has had a 10-kg (22-lb) weight loss during this period. He drinks approximately 1 pint of vodka daily. He appears disinterested, inattentive to his surroundings, and agitated. Ophthalmologic examination shows nystagmus, conjugate gaze palsy, and sluggishly reactive pupils. He walks slowly, with a broad-based gait. Laboratory studies show no abnormalities. Which of the following pathologic findings is most likely to be observed in this patient’s brain?
CorrectIncorrect -
Question 11 of 20
11. Question
A 22-year-old woman is brought to the emergency department 3 hours after being sexually assaulted. The police report that she was alone in her apartment when an intruder broke in and raped her. When the physician meets the patient, the patient says she is so ashamed of what happened that she does not want to talk about it or be examined. Which of the following statements by the physician is likely to be most effective in establishing and maintaining rapport with this patient?
CorrectIncorrect -
Question 12 of 20
12. Question
A 43-year-old man has weakness of the right lower two thirds of the face. Which of the following labeled sites on the photograph of the left hemisphere shown is most likely to be damaged?
 CorrectIncorrect
CorrectIncorrect -
Question 13 of 20
13. Question

A 27-year-old man comes to the physician because of a 3-week history of low-grade fever, night sweats, and nonproductive cough. He has a long history of Crohn disease treated with prednisone. His temperature is 37.9°C (100.2°F), pulse is 89/min, respirations are 16/min, and blood pressure is 132/68 mm Hg. A chest x-ray shows a patchy infiltrate and cavitary lesion in the right upper lobe. Acid-fast staining of a sputum sample is negative for bacilli. A photomicrograph of a silver-stained biopsy specimen of the lesion obtained via bronchoscopy is shown. Which of the following is the most likely causal organism?
CorrectIncorrect -
Question 14 of 20
14. Question
A 26-year-old woman comes to the physician because of a 3-month history of palpitations; she has had a 5.4-kg (12-lb) weight loss during this period. She has had no neck pain. She does not smoke cigarettes or drink alcohol. She is 165 cm (5 ft 5 in) tall and now weighs 48 kg (105 lb); BMI is 18 kg/m2. Her temperature is 37°C (98.6°F), pulse is 110/min, respirations are 18/min, and blood pressure is 100/60 mm Hg. Physical examination shows a nontender, nonpalpable thyroid gland; there is no exophthalmos. Deep tendon reflexes are 3+ and brisk. Serum studies show:
Thyroid-stimulating hormone
<0.1 μU/mL
Thyroxine (T4)
20 μg/dL
Thyroglobulin
2 ng/mL (N=1–25)
Thyroid radioactive iodine uptake
<1%
Which of the following is the most likely cause of this patient’s condition?
CorrectIncorrect -
Question 15 of 20
15. Question
A 29-year-old woman comes to the physician with her husband of 6 months because of pain with vaginal intercourse. She says that she can become aroused, but she is unable to have intercourse because of pain. Pelvic examination is limited because of involuntary spasm of the perineal muscles. Which of the following nerves is most likely involved in this patient’s disorder?
CorrectIncorrect -
Question 16 of 20
16. Question
An 18-year-old man comes to the office because of a 2-year history of pale, scaly areas on the skin of his back and abdomen. He says these areas are more noticeable during the summer months. Physical examination shows scattered 1- to 2-cm patches of hypopigmentation and scarring over the skin of the trunk. Microscopic examination of a scraping of one of these patches mixed with 20% KOH shows fungal hyphae and yeast. The activity of which of the following cutaneous enzymes is most likely inhibited by the fungus?
CorrectIncorrect -
Question 17 of 20
17. Question

A 26-year-old woman (individual II-1 in the pedigree shown) and her 25-year-old husband (individual II-2) come to the office for genetic counseling prior to conception. The husband has a family history of Huntington disease, which has been clinically diagnosed in his mother (individual I-2) and a maternal aunt (individual I-4). Which of the following best represents the probability that this couple’s child (individual III-1) will develop Huntington disease later in life?
CorrectIncorrect -
Question 18 of 20
18. Question
A 43-year-old man comes to the physician for a routine health maintenance examination. His father died of a myocardial infarction at the age of 49 years, and his brother had a myocardial infarction at the age of 41 years. Physical examination shows no abnormalities. Serum lipid and high sensitivity C-reactive protein concentrations are obtained. Based on the results, a drug is prescribed to be taken once daily. One year later, the same serum analysis is performed. The results are shown in the table:
Serum
Initial Visit
One Year Later
HDL-cholesterol
49 mg/dL
52 mg/dL
LDL-cholesterol
108 mg/dL
55 mg/dL
C-reactive protein
4.2 mg/L (N=0.08−3.1)
2.2 mg/L
Which of the following drugs most likely caused the changes in this patient’s serum findings?
CorrectIncorrect -
Question 19 of 20
19. Question
A 58-year-old man is admitted to the intensive care unit for respiratory failure. He is receiving mechanical ventilation. He also had urosepsis that was complicated by aspiration pneumonia. For the past 3 days, the care team has repeatedly attempted to wean the patient from an Fio2 of 1.0, but each time, his Po2 decreases into the 50 to 60 mm Hg range. This patient is at increased risk for damage to type II pneumocytes from which of the following?
CorrectIncorrect -
Question 20 of 20
20. Question
A 20-year-old man comes to the physician for a follow-up examination after blood pressure measurements were 175/105 mm Hg and 185/110 mm Hg 1 and 3 weeks ago, respectively. He is not obese, eats a healthy diet, and does not use illicit drugs. He has no family history of hypertension. His blood pressure now is 180/110 mm Hg. Physical examination shows no other abnormalities. Routine laboratory studies, including serum electrolyte concentrations, show no abnormalities. Antihypertensive treatment is started, but his blood pressure remains elevated at his next visit 3 weeks later, and his plasma renin activity is markedly increased in the left renal vein compared with the right renal vein. Renal angiography shows a pattern of “peaks and valleys” in the left renal artery. Which of the following is the most likely diagnosis?
CorrectIncorrect
